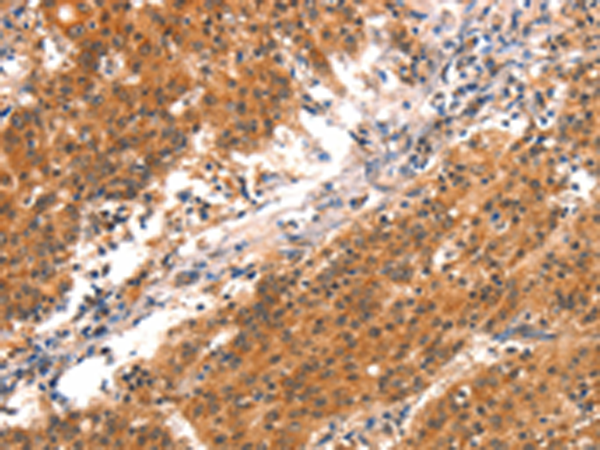
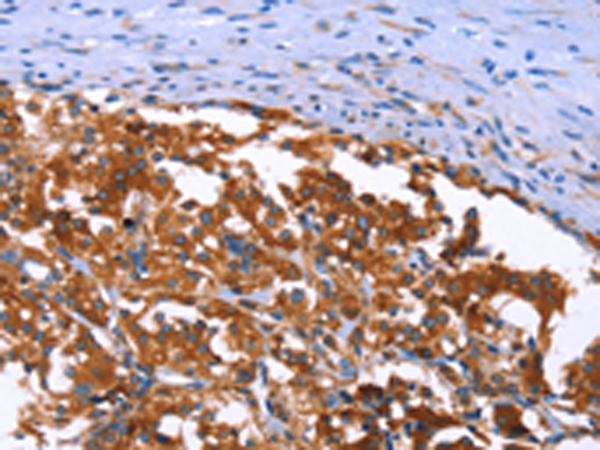

-
分类: 科研抗体货号: P11190别名: APC1; MCPR; TSG24应用: IHC反应种属: Human, Mouse
-
分类: 科研抗体货号: P11240别名: BCM; BCMA; CD269; TNFRSF13A应用: WB,IHC反应种属: Human, Mouse
-
分类: 科研抗体货号: P11224别名: cGKII; PRKGR2应用: WB,IHC反应种属: Human, Mouse, Rat
-
分类: 科研抗体货号: P11239别名: BCL5; LAZ3; BCL6A; ZNF51; ZBTB27应用: WB,IHC反应种属: Human, Mouse
-
分类: 科研抗体货号: P11222别名: H-SGK2; dJ138B7.2应用: WB,IHC反应种属: Human, Mouse, Rat
-
分类: 科研抗体货号: P11238别名: BCL4; D19S37应用: IHC反应种属: Human, Mouse
-
分类: 科研抗体货号: P11221别名: RSK4; PP90RSK4应用: IHC反应种属: Human
-
分类: 科研抗体货号: P11236别名: CAS; CAS1; CASS1; CRKAS; P130Cas应用: WB,IHC反应种属: Human, Mouse, Rat
-
分类: 科研抗体货号: P11219别名: HORK3; P2Y12; ADPG-R; BDPLT8; SP1999; P2T(AC); P2Y(AC); P2Y(12)R; P2Y(ADP); P2Y(cyc)应用: IHC反应种属: Human
-
分类: 科研抗体货号: P11216别名: PICK; PRKCABP应用: IHC反应种属: Human, Mouse, Rat

鄂公网安备42018502007531号
鄂公网安备42018502007531号

